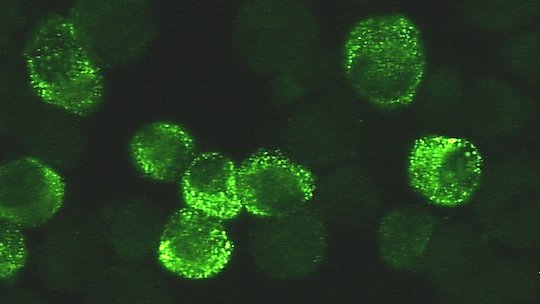
Lassaviren unterm Fluoreszenz-Mikroskop

Infektiöse Lassa-Viren überdauern im Sperma genesener Männer
Forschungsteam um ISTH und BNITM veröffentlicht Ergebnisse umfassender Langzeitstudie in Nigeria
Irrua/ Hamburg. Die Mensch-zu-Mensch-Übertragung von Lassa-Viren kann über Tröpfcheninfektion und Körperflüssigkeiten erfolgen. Bisher gibt es allerdings noch keine Erkenntnisse, ob das Virus auch sexuell übertragen werden kann. Eine internationale institutionenübergreifende Forschungsgruppe des Irrua Specialist Teaching Hospital (ISTH) und des Bernhard-Nocht-Instituts für Tropenmedizin (BNITM) hat nun in einer prospektiven Langzeitstudie herausgefunden, dass infektiöse Lassa-Viren ähnlich wie Ebola-Viren noch monatelang im Sperma genesener Männer überdauern können. Die Ergebnisse sind im Wissenschafts-Journal The Lancet Microbe erschienen.
Originalpublikation:doi.org/10.1016/S2666-5247(21)00178-6
Das Lassafieber ist wie die Ebola-Viruskrankheit eine hämorrhagische Fiebererkrankung. Das heißt, sie kann zu gefährlichen inneren Blutungen führen. Krankheitserreger ist das Lassa-Virus, das in verschiedenen Ländern West-Afrikas vorkommt. Hauptansteckungsquelle ist die in Afrika weit verbreitete Natal-Vielzitzenmaus (Mastomys natalensis). Das Virus kann aber auch von Mensch zu Mensch übertragen werden. Viele Lassa-Virusinfektionen verlaufen mild, jedoch ist die Sterblichkeitsrate mit 20 bis 30 Prozent unter den ins Krankenhaus eingewiesenen Patient:innen relativ hoch. In Westafrika stecken sich schätzungsweise bis zu 300.000 Menschen pro Jahr mit dem Lassa-Virus an, bis zu 5.000 Erkrankte sterben an den Folgen der Infektion. Hinzu kommt: Lassafieber hat epidemisches Potenzial. Das Virus hat eine Inkubationszeit von bis zu 21 Tagen, und bisher gibt es weder einen Impfstoff noch eine spezifische medizinische Behandlung.
Das Lassa-Virus wird daher international in die höchste biologische Risikogruppe 4 eingestuft, und in den betroffenen Ländern gibt es nur eine begrenzte Anzahl von Laboren mit angemessenen Schutzmöglichkeiten. Dies nehmen Länder wie Nigeria zwar in Angriff, doch die begrenzten Testkapazitäten erschweren die Diagnose, das Management von Patient:innen und die Erforschung des Virus. Wissenschaftler:innen des Irrua Specialist Teaching Hospital (ISTH) im nigerianischen Bundesstaat Edo und der Abteilung Virologie des Bernhard-Nocht-Instituts für Tropenmedizin (BNITM) in Hamburg haben nun Studienergebnisse veröffentlicht, die die Nachsorge von Lassa-Fieber-Genesenen und die Infektionsprävention deutlich verbessern könnten.

Bisher war nicht bekannt, ob und wie lang infektiöse Lassa-Viren nach überstandener Krankheit in unterschiedlichen Körperflüssigkeiten überdauern können. Das Forschungsteam um den Studienleiter Dr. Ephraim Ogbaini-Emovon vom ISTH und die Virologin Dr. Anke Thielebein vom BNITM hat daher über einen Zeitraum von zwei Jahren wiederholt verschiedene Körperflüssigkeiten Genesener analysiert: Blutplasma, Speichel, Urin, Tränenflüssigkeit, und Vaginalsekret oder Sperma. Von den 165 Studienteilnehmer:innen wurden die Daten von 159 in die Analyse eingeschlossen. Neun Mal nach ihrer Entlassung kehrten die ehemaligen Patient:innen nach Ihrer Entlassung an die ISTH-Tagesklinik zurück. Zusätzlich zu den Abstrichen und Probenentnahmen wurden sie jedes Mal systematisch zu ihrem Befinden befragt und eingehend untersucht. Anschließend testeten die Forschenden, ob und wie viel Genmaterial (RNS) des Lassa-Virus sich in den Proben befindet.

Insgesamt hat das Studienteam am ISTH mehr als 4.800 Proben analysiert. Im ersten Monat nach Entlassung fand es geringe Mengen Lassa-Virus-RNS in 26 Prozent der Plasma- und in 19 Prozent der Urinproben sowie in 3 Prozent der Speichelproben, 4 Prozent der Augen- und 9 Prozent der Vaginalabstriche. Spätestens drei Monate nach der Entlassung waren alle Proben dieser Körperflüssigkeiten negativ.
Im Gegensatz dazu befanden sich innerhalb des ersten Monats in über 70 Prozent der gesammelten Spermaproben konstant hohe Konzentrationen von Lassa-Virus-RNS. Sechs Monate nach Entlassung waren immer noch knapp 20 Prozent der Proben positiv, 2 Prozent blieben es bis zu zwölf Monate nach der Genesung. Insgesamt dreiviertel aller Studienteilnehmer, die Spermaproben abgegeben hatten, waren zu mindestens einem Zeitpunkt positiv - eine deutliche Mehrheit. In einer mathematischen Modellierung der Daten errechneten die Forschenden, dass 83 Tage nach Entlassung noch in 50 Prozent und 193 Tage nach Entlassung noch in 10 Prozent der Genesenen Lassa-Virus-RNS im Sperma nachgewiesen werden kann.
Aber repräsentiert diese RNS infektiöses Virus? Um das zu klären, versuchte Dr. Thielebein im Hochsicherheitslabor der Stufe 4 am BNITM vermehrungsfähiges Virus aus den positiven Proben zu isolieren. Dazu gab sie diese auf Zellen und applizierte sie in immunsupprimierte Mäuse. Interessanterweise konnte sie aus mehr als der Hälfte der getesteten Spermaproben infektiöses Lassa-Virus isolieren, darunter auch aus Proben, die sechs und neun Monate nach Entlassung gesammelt worden waren. Aus den anderen Körperflüssigkeiten, die nur während des ersten Monats nach der Entlassung RNS enthielten, konnte sie dagegen kein infektiöses Virus isolieren.
Zudem fand das Forschungsteam eine Korrelation zwischen Schwere der Erkrankung und der Persistenz des Virus im Sperma: Im Vergleich zu der Gruppe mit kurzer Verbleibedauer (maximal ein Monat nach Entlassung) waren die Genesenen mit verlängerter Verbleibedauer (drei Monate und länger nach Entlassung) länger im Krankenhaus geblieben, hatten zu Beginn ihrer Krankheit eine höhere Viruslast und zeigten eine stärkere Organbelastung. Das heißt, je schwerer die Studienteilnehmer erkrankt waren, desto länger hatte das Virus anschließend in ihrem Sperma überdauert.
Dr. Anke Thielebein:„Unsere Studienergebnisse zeigen, dass für männliche Überlebende einer Lassa-Fieber-Erkrankung ein beachtliches Risiko besteht, infektiöses Lassa-Virus über einen langen Zeitraum in ihrem Sperma zu behalten. Vor allem Männer, die schwer erkrankt waren, sollten gezielt darüber aufgeklärt werden, dass noch sechs bis neun Monate nach ihrer Genesung die Gefahr besteht, das Virus potenziell sexuell zu übertragen. Ihnen sollte unbedingt die Gelegenheit zur Nachuntersuchung gegeben und für angemessene Schutzmaßnahmen ermöglicht werden. Und auch Frauen sollten nach ihrer Entlassung aus dem Krankenhaus noch einige Monate nur geschützten Geschlechtsverkehr haben.“


Dr. Ephraim Ogbaini-Emovon: „Diese Studie ist neuartig! Es ist die erste, die zeigt, dass Lassa-Fieber potenziell sexuell übertragbar ist. Unsere Ergebnisse haben Auswirkungen auf die sexuelle Gesundheit, die Infektionskontrolle und die öffentliche Gesundheit. Wir verfügen nun über Belege für die Empfehlung von Barriere-Methoden zur Verhütung sexuell übertragbarer Krankheiten, z. B. die Verwendung von Kondomen für männliche Lassa-Fieber-Überlebende. Darüber hinaus werden sexuelle Gesundheitsaufklärung, Beratung, Nachuntersuchungen und Testungen von männlichen Überlebenden empfohlen, um die Übertragung der Krankheit in der Gemeinschaft zu verhindern. Darüber hinaus bilden die Ergebnisse dieser Studie eine gute Grundlage für weitere Studien über die klinischen Auswirkungen des persistierenden Virus im männlichen Fortpflanzungssystem.“
Das Forschungsteam untersucht weiterführend, wie die langfristige Immunantwort nach einer überstandenen Lassa-Fieber Erkrankung aussieht. Dazu ermitteln sie mit serologischen Methoden die Antikörperspiegel gegen verschiedene Virus-Antigene und untersucht deren Fähigkeit zur Virus-Neutralisierung. Eine Korrelationsanalyse des Immunprofils mit der Schwere des Krankheitsverlaufes und der Virus-Persistenz im Sperma könnte weitere mögliche Risikofaktoren identifizieren.
Prof. Sylvanus Okogbenin, Leitender Ärztlicher Direktor des ISTH: „Diese von Wissenschaftler:innen des ISTH und des BNITM durchgeführte Forschungsarbeit ist ein Beleg für die Entwicklung von Kapazitäten, die in den mehr als zehn Jahren der Forschungszusammenarbeit zwischen unseren Einrichtungen stattgefunden hat. Die Beziehung verkörpert die lang ersehnte Nord-Süd-Forschungskooperation. Die Ergebnisse deuten darauf hin, dass es neben Sperma noch andere Körperflüssigkeiten geben könnte, in denen sich das Lassa-Virus monatelang aufhalten könnte. Dies hat Auswirkungen auf die gesamte Lassa-Fieber-Behandlung und -Nachsorge. Abschließend bin ich der Meinung, dass diese Ergebnisse die Notwendigkeit unterstreichen, die Entwicklung eines Impfstoffs gegen das Lassa-Virus als kosteneffektives Mittel zur Prävention zu fördern.“
Dr. Chikwe Ihekweazu, Generaldirektor des nigerianischen Zentrums für Seuchenkontrolle: „Die von den Wissenschaftler:innen des ISTH und des BNITM durchgeführten Forschungsarbeiten liefern weiterhin dringend benötigte Erkenntnisse für die Prävention und Kontrolle von Lassa-Fieber-Ausbrüchen. Wir sind stolz auf den wachsenden Beitrag Nigerias zur weltweiten Lassa-Fieber-Forschung und die Zusammenarbeit mit Institutionen wie dem BNITM, die unsere wissenschaftlichen und gesundheitspolitischen Ziele unterstützen. Neben der exzellenten Wissenschaft entwickeln wir die Kapazitäten von Wissenschaftler:innen, die Nigeria braucht, um sich kontinuierlich an der weltweiten Forschung und Entwicklung zu beteiligen.“
HINTERGRUND
Über das Bernhard-Nocht-Institut für Tropenmedizin
Das Bernhard-Nocht-Institut für Tropenmedizin (BNITM) ist Deutschlands größte Einrichtung für Forschung, Versorgung und Lehre auf dem Gebiet tropentypischer und neu auftretender Infektionskrankheiten. Aktuelle Forschungsschwerpunkte bilden Malaria, hämorrhagische Fieberviren, Immunologie, Epidemiologie und Klinik tropischer Infektionen sowie die Mechanismen der Übertragung von Viren durch Stechmücken. Für den Umgang mit hochpathogenen Viren und infizierten Insekten verfügt das Institut über Laboratorien der höchsten biologischen Sicherheitsstufe (BSL4) und ein Sicherheits-Insektarium (BSL3). Das BNITM umfasst das nationale Referenzzentrum für den Nachweis aller tropischen Infektionserreger und das WHO-Kooperationszentrum für Arboviren und hämorrhagische Fieberviren. Gemeinsam mit dem ghanaischen Gesundheitsministerium und der Universität von Kumasi betreibt es ein modernes Forschungs- und Ausbildungszentrum im westafrikanischen Regenwald, das auch externen Arbeitsgruppen zur Verfügung steht.
Ansprechperson
Dr. Anke Thielebein
Telefon : +49 40 285380 938/932
E-Mail : thielebein@bnitm.de
Dr. Ephraim Ogbaini-Emovon
ISTH
Telefon : +234 805 806 5577
E-Mail : epogbaini@yahoo.com
Dr. Eleonora Schönherr
Presse- & Öffentlichkeitsarbeit
Telefon : +49 40 285380-269
E-Mail : presse@bnitm.de
Julia Rauner
Presse- & Öffentlichkeitsarbeit
Telefon : +49 40 285380-264
E-Mail : presse@bnitm.de